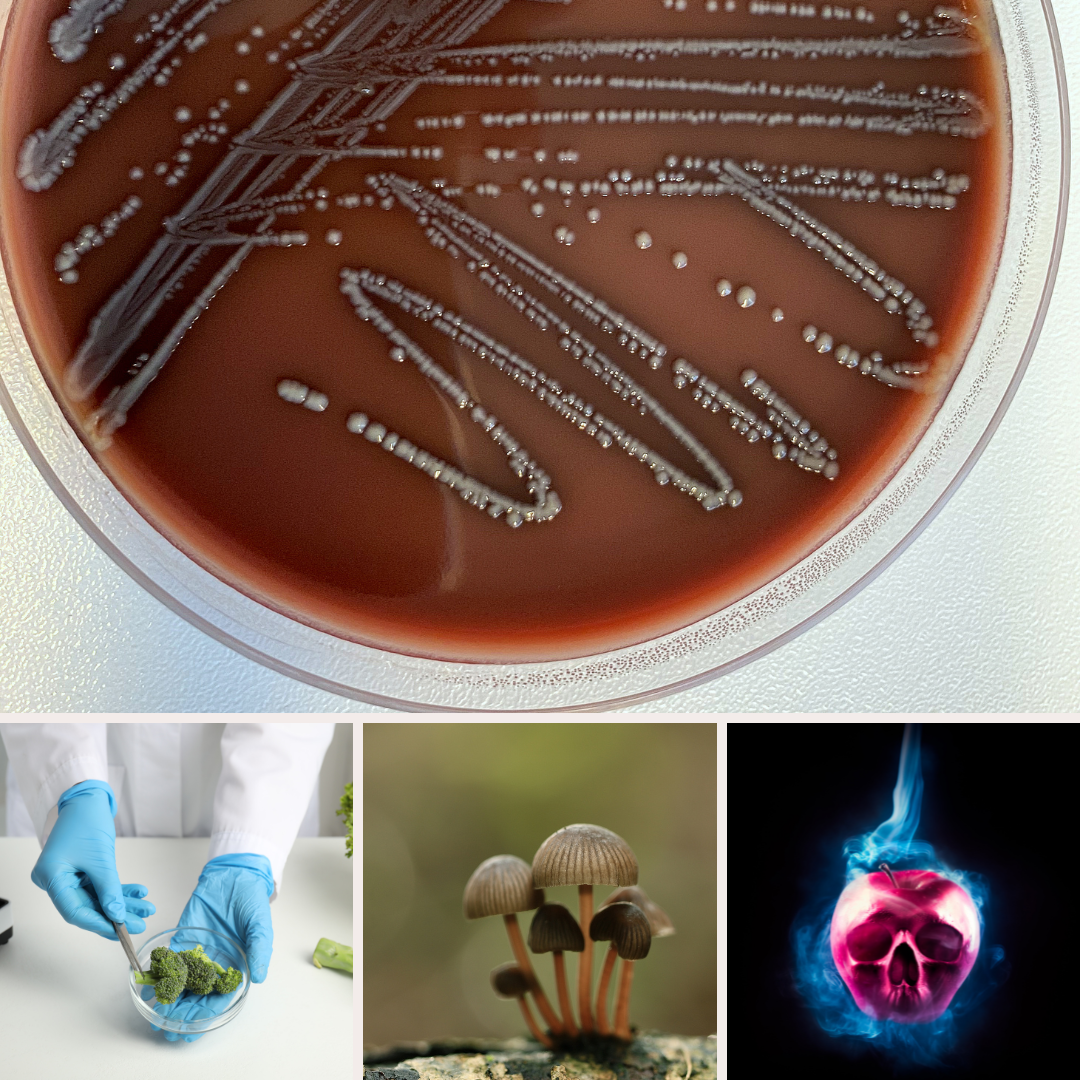

요약
조리된 음식을 상온에 방치한 이후에 먹을 경우 '바실러스 세레우스’라는 균에 감염되며 발생하는 식중독을 볶음밥 증후군이라고 말한다. 바실러스 세레우스는 쌀, 파스타면 등 탄수화물이 많이 함유된 식품에서 특히 잘 증식하는 식중독균이다.
볶음밥 증후군
볶음밥 증후군은 조리된 음식을 상온에 방치한 뒤 섭취할 때 발생하는 식중독을 의미합니다. 이 식중독은 '바실러스 세레우스'라는 세균에 의해 유발됩니다. 바실러스 세레우스는 토양 세균 중 하나로, 주로 쌀이나 파스타와 같은 탄수화물이 많이 함유된 음식에서 번식합니다.
특징
주목할 점은 이 세균이 고온에서도 살아남을 수 있다는 것입니다. 예를 들어, 135℃ 이상의 온도에서 4시간 이상 가열해도 세균이 사멸하지 않습니다. 또한 건조식품에서도 장기간 생존할 수 있다는 점이 중요합니다.
증상
식중독의 증상은 다양한데, 주로 설사나 구토와 같은 소화기 증상이 나타납니다. 이러한 증상은 세균이 만들어내는 독소에 의해 발생합니다.

예방
식중독을 예방하기 위해서는 조리된 음식을 냉장고에 보관하는 것이 중요합니다. 상온에서 음식을 오랫동안 방치하지 않고, 신선한 상태로 보관하도록 노력해야 합니다. 특히 볶음밥과 같이 탄수화물이 많이 함유된 음식은 세균 번식에 적합한 환경이므로 주의가 필요합니다.
이러한 안전수칙을 지키면서 식중독으로부터 안전한 식사를 즐기세요.
식중독을 일으키는 5가지 주요 균
1. 살모넬라균 (Salmonella):
- 특징: 닭고기, 계란, 유제품 등에서 발견되며, 소화기 증상을 유발합니다.
- 예방 방법: 신선한 식품을 선택하고, 식품을 완전히 익히는 것이 중요합니다. 식품 조리 후 바로 냉장고에 보관하고, 식품을 다룰 때 손을 깨끗하게 씻어야 합니다.
2. 대장균 (Escherichia coli):
- 특징: 오염된 물이나 음식을 통해 인체에 침입하여 식중독을 일으키는 경우가 있습니다.
- 예방 방법: 식품 조리 시에는 완전히 익히고, 식중독 예방을 위해 손을 자주 씻는 것이 중요합니다. 물 소비 시에는 깨끗한 물을 선호하고, 외부에서 오염된 물을 섭취하지 않아야 합니다.
3. 스티포토코커스균 (Staphylococcus):
- 특징: 피부나 코 등에서 발생하는 균주가 식중독을 유발하며, 식품 오염 시 식중독이 발생할 수 있습니다.
- 예방 방법: 식중독을 일으키는 균을 피하기 위해 식품 조리 전에 손을 깨끗하게 씻고, 식중독이 가능성이 있는 식품은 냉장고에 보관합니다. 조리 시 식품이 자외선이나 공기 중 균에 노출되는 것을 최소화해야 합니다.
4. 바실러스 세레우스 (Bacillus cereus):
- 특징: 주로 탄수화물이 풍부한 식품에서 번식하며, 볶음밥과 같은 음식에서 주로 발견됩니다.
- 예방 방법: 식품을 조리한 후에는 냉장고에 빨리 보관하고, 식중독의 원인이 될 수 있는 음식을 오랫동안 상온에 방치하지 않아야 합니다.
5. 리스테리아균 (Listeria):
- 특징: 미생물 오염된 식품을 섭취하면 식중독을 일으키는데, 특히 임산부나 노인, 면역력이 약한 사람들에게 심각한 영향을 줄 수 있습니다.
- 예방 방법: 식품 조리 시에는 식품 안전에 유의하고, 오랫동안 보관되거나 오래된 식품은 섭취하지 않는 것이 좋습니다. 식품을 조리한 후에는 냉장고에 빨리 보관해야 합니다.
위 방법들을 준수하면서 식중독을 예방하는 데 도움이 될 거예요. 안전한 음식 조리와 보관이 중요합니다!
함께 읽으면 좋은 글
2024.04.27 - [건강하게 살자] - 백일해 (pertussis)
백일해 (pertussis)
호흡기 감염 질환정의백일해는 보르데텔라 백일해균(Bordetella pertussis)에 의해 유발되는 호흡기 질환으로, 특징적인 기침 양상과 함께 14일 이상 지속되는 증상을 보입니다. 주로 어린이에서 발생
start.2jowon.com
2024.04.26 - [건강하게 살자] - 피부 노화 예방 자외선 차단 꿀팁
피부 노화 예방 자외선 차단 꿀팁
피부 건강을 위한 야외 활동 꿀팁자외선과 피부 건강햇볕 아래 야외 활동은 정말 기분 좋은 일이지만, 자외선은 신경 써야 할 부분입니다. 자외선 A는 피부 깊은 곳까지 침투하여 주름을 유발하
start.2jowon.com
2024.04.25 - [건강하게 살자] - 대상포진에 대하여 알아봅시다
대상포진에 대하여 알아봅시다
대상포진: 신경 발작으로 인한 발진 질병사람 몸의 신경절에 잠복상태로 있던 수두-대상포진 바이러스가 다시 활성화되면서 발생하는 질병 발생 메커니즘:대상포진은 몸 안에 잠복한 수두-대상
start.2jowon.com
'건강하게 살자' 카테고리의 다른 글
| 어린이 가정 안전사고의 유형 및 원인 (2) | 2024.05.01 |
|---|---|
| 여름철, 에어컨 및 제습기 유지 관리 요령 (0) | 2024.04.29 |
| 백일해 (pertussis) (0) | 2024.04.27 |
| 피부 노화 예방 자외선 차단 꿀팁 (0) | 2024.04.26 |
| 대상포진에 대하여 알아봅시다 (0) | 2024.04.25 |